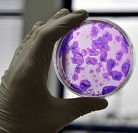

Voilà une nouvelle prouesse dans le domaine de la médecine. Une équipe de chercheurs japonais vient en effet de révéler avoir créé des tissus de reins à partir de cellules souches pluripotentes induites (iPS). C’est une annonce de taille puisqu’il s’agit d’une première mondiale.
Ce succès on le doit à l’équipe du professeur Kenji Osafune, en collaboration avec le Centre de l’Université de Kyoto destiné à la recherche et les applications des cellules iPS. Le tissu rénal, ou plutôt le tissu mésoderme intermédiaire qui le compose en grande partie, est généré après 11 jours de culture avec un taux de réussite de 90 %.
Cette reconstitution est rendue possible grâce aux progrès de la médecine régénérative et au grand potentiel qu’offrent les cellules souches. Le travail des scientifiques va évidemment dans ce sens. Ici il consiste à faire revenir des cellules adultes à l’état quasi embryonnaire. Par souci éthique, les cellules sont prélevées sur des êtres humains adultes puis reprogrammées en laboratoire. Ainsi, les cellules dites induites à la pluripotence, par leur « immaturité », ont la capacité de se transformer en n’importe quelle cellule en fonction du milieu dans lequel elles se trouvent.
Il n’y a pas encore de garantie quant à la guérison des maladies rénales par greffes de cellules régénérées souligne le Dr Osafune. L’utilisation de ces cultures pour un traitement médical n’est donc pas à l’ordre du jour. Une telle affirmation serait prématurée au vu de l’avancement des travaux. La recherche tend néanmoins vers la maîtrise de cette méthode et à déterminer, là est le hic, leur propension à développer des cancers. Et bien que le rein ait par nature une structure complexe, cela demeure un véritable espoir.
Sources :
Par Sébastien Tribot

Réagissez à cet article
Connectez-vous
Vous avez déjà un compte ? Connectez-vous et retrouvez plus tard tous vos commentaires dans votre espace personnel.
Vous n'avez pas encore de compte ?
Inscrivez-vous !